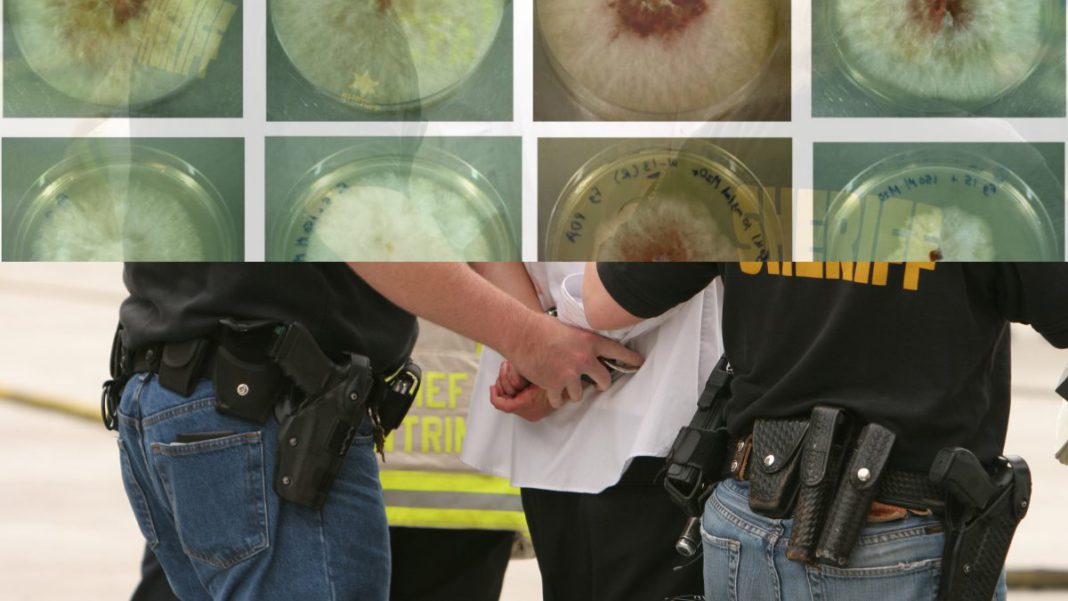

Two Chinese nationals have been charged in the United States with smuggling a dangerous fungus classified as a potential agroterrorism weapon, raising serious national security concerns and prompting strong reactions from federal authorities.
Confirming the arrest, Kash Patel, Director of the FBI, praised the efforts of the FBI Detroit Counterintelligence Task Force and CBP, “The individual, Yunqing Jian, is alleged to have smuggled a dangerous fungus… into the U.S. to research at the University of Michigan. Evidence also indicates she had expressed loyalty to the Chinese Communist Party and had received funding from the Chinese government.” Patel added:
“Your FBI will continue working tirelessly to be on guard against it.”
Yunqing Jian, 33, and Zunyong Liu, 34—both citizens of the People’s Republic of China—face multiple federal charges including conspiracy, smuggling goods into the United States, making false statements, and visa fraud.
The announcement was made by United States Attorney Jerome F. Gorgon Jr., alongside FBI Detroit Special Agent in Charge Cheyvoryea Gibson and CBP Director of Field Operations Marty C. Raybon.
Jian was arrested by the FBI in connection with the illegal import of Fusarium graminearum, a highly noxious fungus that attacks wheat, barley, maize and rice. Known to cause “head blight,” the fungus produces toxins that can lead to vomiting, liver damage, and reproductive harm in humans and livestock. The pathogen has also been blamed for billions of dollars in agricultural losses globally, and is classified in scientific literature as a potential agroterrorism weapon.
Federal authorities allege Jian, who worked at a University of Michigan lab, received Chinese government funding for her research on the fungus and maintained documented allegiance to the Chinese Communist Party. Investigators say her boyfriend, Liu—himself a researcher at a Chinese university—first denied, then admitted to smuggling the fungus through Detroit Metropolitan Airport for study at the same U.S. university.
“This case is of the gravest national security concerns,” said Attorney Gorgon.
“These individuals stand accused of covertly bringing a potential agroterrorism agent into the American heartland under the guise of academic research.”
FBI Special Agent in Charge Cheyvoryea Gibson said,
“These individuals exploited their access to laboratory facilities at a local university to engage in the smuggling of biological pathogens, an act that posed an imminent threat to public safety.”
CBP’s Marty Raybon stressed the broader impact of the plot, calling it “indicative of CBP’s critical role in protecting the American people from biological threats that could devastate our agricultural economy and cause harm to humans.”
Patel alos echoed the gravity of the case, stating,
“This is a sobering reminder that the CCP is working around the clock to deploy operatives and researchers to infiltrate American institutions and target our food supply, which would have grave consequences… putting American lives and our economy at serious risk.”
Jian is expected to appear this afternoon in federal court in Detroit for her initial hearing. Authorities remind the public that a complaint is only an allegation, not evidence of guilt, and a formal indictment decision will follow the completion of the investigation.
The FBI and U.S. Customs and Border Protection are leading the case.
Support our Journalism
No-nonsense journalism. No paywalls. Whether you’re in Australia, the UK, Canada, the USA, or India, you can support The Australia Today by taking a paid subscription via Patreon or donating via PayPal — and help keep honest, fearless journalism alive.